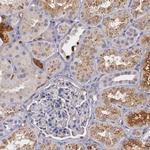
PTS Antibody in Immunohistochemistry (IHC)

Search
Invitrogen
PTS Polyclonal Antibody
{{$productOrderCtrl.translations['antibody.pdp.commerceCard.promotion.promotions']}}
{{$productOrderCtrl.translations['antibody.pdp.commerceCard.promotion.viewpromo']}}
{{$productOrderCtrl.translations['antibody.pdp.commerceCard.promotion.promocode']}}: {{promo.promoCode}} {{promo.promoTitle}} {{promo.promoDescription}}. {{$productOrderCtrl.translations['antibody.pdp.commerceCard.promotion.learnmore']}}
产品信息
PA5-51586
种属反应
宿主/亚型
分类
类型
抗原
偶联物
形式
浓度
规格
纯化类型
保存液
内含物
保存条件
运输条件
RRID
产品详细信息
Immunogen sequence: RCQAQVSRRI SFSASHRLYS KFLSDEENLK LFGKCNNPNG HGHNYKVVVT VHGEIDPATG MVMNLADLKK YMEEAIMQPL DHKNLDMDVP YFADVVSTTE NVAVYIWDNL QKVLPVGVLY KVKVYETDNN IV
Highest antigen sequence identity to the following orthologs: Mouse - 83%, Rat - 84%.
靶标信息
The tetrahydrobiopterin (BH4) cofactor is essential for hepatic hydroxylase, which is involved in phenylalanine degradation and catecholamine and serotonin biosynthesis. BH4 is also an essential and limiting cofactor for all types of nitric oxide synthase. BH4 deficiency results in hyperphenylalaninemia and monoamine neurotransmitter depletion and is most commonly due to autosomal recessive mutation in 6-pyruvoyltetrahydropterin synthase (PTPS), the second enzyme for BH4 biosynthesis. The active site of PTPS consists of the pterin-anchoring Glu A107 neighbored by two catalytic motifs: a Zn(II) binding site and an inter-subunit catalytic triad formed by Cys A42, Asp B88 and His B89. The active site of PTPS undergoes a Zn and Mg-dependent reaction that includes a triphosphate elimination, a stereospecific reduction and the oxidation of both side hydroxyl groups. The catalytic triad of PTPS is involved in the deprotonation of the side-chain carbons of substrates. In addition, Ser 19 of human PTPS may be a substrate for cGMP-dependent protein kinase type II phosphorylation in vivo, which is essential for normal activity of PTPS.
仅用于科研。不用于诊断过程。未经明确授权不得转售。
篇参考文献 (0)
生物信息学
蛋白别名: 6-pyruvoyl tetrahydrobiopterin synthase; c.164_186del in 6-pyruvoyltetrahydropterin synthase PTPS gene P.(Val55Aspfs*2); PTP synthase; Thr67Met; Val55Aspfs*2; Val55Aspfs*2 and Arg8Cys; Val55Aspfs*2 and Lys29Ile; Val55Aspfs*2 and Thr67Met
基因别名: PTPS; PTS
UniProt ID: (Human) Q03393
Entrez Gene ID: (Human) 5805